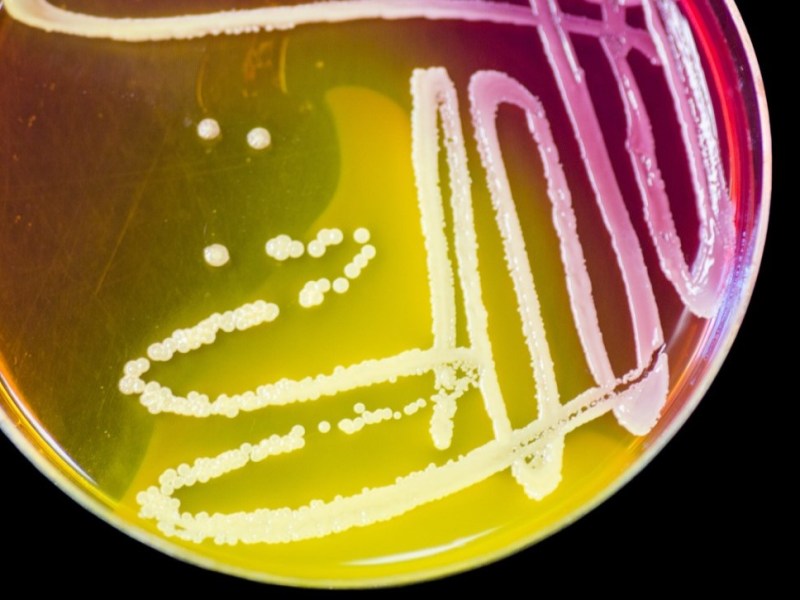
Why scientists need to create GMOs for their research in the&nbsp;lab

Science Bites

Hungry for Science
How exercise can prevent dementia
Mental fitness even in old age; physical activity can help with that.
[Small bite] Why are leaves green?
Waarom zijn bladeren eigenlijk groen en hoe komt het dat ze van kleur veranderen in de herst?
Treating cancer with mRNA
We all know mRNA as a vaccine against corona by now. But this technology can be used for much more, possibly also to treat cancer.
Vulture bees: Honey made from rotten meat
They look like normal bees, but they have strange eating habits. Instead of pollen and nectar, vulture bees go for rotting flesh.
Vaccine prevents HIV infection in woman efficiently
An injection every two months, instead of a pill every day. Medication to prevent an HIV-infection is becoming more effective, while administration is more convenient and protects those most at risk in sub-Saharan Africa: young woman.
Cave Art on Drugs
The images in cave paintings were long believed to be strongly influenced by the consumption of hallucinogenic substances. New scientific findings have researchers question this theory.
When the brain causes stomach pain
The connection between brain and intestines: How stress and depression can affect gut health.
Reforestation under the sea
Seagrass is among the most important marine plants, as it harbors whole ecosystems and also stores carbon dioxide. Areas in which these underwater meadows grow have declined drastically, US scientists started a reforestation campaign, to give endangered species a new habitat and to fight climate crisis.
Broad beans support bumblebee population
Bumblebees benefit from broad bean plants. By planting these crops, the declining bumblebee population can be increased again.
Fuel – out of thin air
About new ways to produce climate-neutral fuels: another ace up our sleeves in the fight against climate crisis.
Health trend intermittent fasting
What is behind the promise of a leaner, healthier self by refraining from eating?
I want you to wash your hands!
The number of people that called in sick with a cold has declined due to social distancing and increased hygiene efforts. So, why don’t we turn these measures into habits that we stick to, even after the pandemic.
Doctors cure hereditary blood diseases with CRISPR-Cas
Three patients with hereditary blood diseases have been cured by a new gene therapy with CRISPR-Cas, where doctors modified the DNA of red blood cell precursors.
Eyesight generated in the petri-dish
Scientists restore light perception of blind mice by transplanting light sensing cells, which they made from skin.
Winners of climate crisis!?
While polar bears and seals continuously struggle to survive with reduced extents of sea ice in the Arctic, penguins in the Antarctic have higher hunting and breeding success, when there is less ice.
Mouse mother’s diet influences adult offspring’s weight
A dietary study on pregnant mice shows how fiber consumption influences the metabolic development of their offspring, thus determining their health and weight as adults. These findings could apply to humans as well.
PhD student: “I feel stupid for not knowing more”
PhD student Heidemeyer suffers from imposter syndrome: ‘I am afraid that people will think that I am not smart enough’. She opens up about her experiences.
Inheritance of trauma
Trauma can have long lasting effects on a person’s psyche, but it can also change their genetic material. This way, trauma is inheritable and makes the generations to follow more susceptible for disease and mental disorders.
Research on golden poop for golden doog food
The poop of a dog says a lot about the quality of the food it is eating. In order to produce gold standard pet food, scientists analyze doog poop.
Fish change rapidly through cave life
Fish living in dark caves have rapidly adapted to their environment during evolution. New research shows that some of those changes occur within two years, without mutations to the DNA.
The link between motivation and biochemistry allows for lifelong learning
The ability to learn does not stop with childhood. It is possible to acquire new skills with motivation, even in old age, brain researchers report.
Fluorescent beads show the structure of food
Researchers have developed a method that determines the structure of foodstuffs at a molecular level with the help of tiny fluorescent beads.
An apple or a pill per day, which keeps the doctor away?
Vitamins and minerals are very important for our health, but it is not so easy to eat enough fruits and vegetables. Nutrient pills are a welcome alternative, but can they compensate for a balanced diet?
Decision making without a brain – The secret messengers of plants
How do you make decisions if you cannot think? How do you respond to danger if you cannot run or hide? Plants know the answer to these questions. And fundamental researchers all over the world try to understand them as well.
First lure, then kill: beating the malaria mosquito
A new malaria control method focuses on female mosquitoes and her eggs.
Sun cream for trees?!
Last month, in the Dutch town of Doetinchem, nature managers applied sun cream onto the bark of beech trees. Is that really necessary?
Sleep study on fruit flies helps to understand brain development
The brains of adolescent fruit flies are wired to make them sleep longer than adults, which is important for brain development. Scientists believe that human brains work similarly and that this is the reason why children and teenagers sleep longer.
I was wrong – online conferences
A few years ago one of my colleagues wondered why we still travel the world to attend conferences. I immediately jumped on the conversation and passionately argued that physical gatherings are necessary for science. I was completely convinced that I was right.
Are 5 servings of fruits and vegetables a day really necessary?
The body needs vitamins and minerals to carry out many vital processes. We therefore must eat them regularly, but in which quantities?
Exposed – the imposter syndrome
Do you know that feeling that everyone around you knows exactly what they are doing, while you’re just muddling on? Many people, in all kinds of professions, suffer from this so-called imposter syndrome. Even scientists, and especially PhD students, struggle with this.
Corona virus crisis: necessity is the mother of invention
Time pressure for the development of a corona virus vaccine makes researchers utilize new techniques. These promise shorter production times. But how will scientists know whether they are affective?
Making a Lava Lamp
Here, we will show you how you can make your own temporary lava lamp with household items. It is a fun and easy experiment suitable for those in need to entertain their kids in these corona isolation times and those who want to let out their inner child and be mesmerized by science.
Salamander wears coat of toxic bacteria
The poisonous rough-skinned newt Taricha granulosa, which can kill an adult human, turns out not to be poisonous itself. The poison is made by its little helpers.
Shedding light on butterflies
Butterflies come in all shapes and colors. Mother Nature has tricks to color those butterflies as well as the rest of the world.
Scientists forge weapons for the fight against corona virus
Scientists are researching feverishly to find solutions for the corona crisis. And they seem to have found a promising one.
How knowledge of photosynthesis leads to production of clean energy.
From fundamental research to an application
Are honey and maple syrup healthy replacements for refined sugars?
Studies have shown that natural sweeteners (honey and maple syrup) interfere less with our blood glucose levels than refined sugar. They are thus considered to be healthy. However, this is only a small piece in the puzzle of nutritional science, the overall picture looks a little different.
The latest news in Alzheimer’s research
Methods that allow an early diagnosis of Alzheimer’s disease are as important as a good therapy
The crisis of growing up
Quarter life crisis: Why so many young people find it hard to settle down and how one can make satisfying decisions.
Viruses as ally? Are they going to optimize our gut flora?
Both good and bad bacteria in our gut affect our health. Can’t we kill those bad bacteria?
Scientists forget an important component in the hunt for the corona vaccine
Scientists have published numerous 3D models of parts of the coronavirus. Those models are essential in making a corona vaccine. But they are missing something important …
Boredom by corona isolation? Become a scientist for a day (or longer).
Scientists place large amounts of data in the app and call on us to analyze it. This allows you to contribute to your favorite field, for example biology, art, astronomy or health.
Scientists strike back: are we outsmarting malaria?
The malaria pathogen is building up resistance to current medications. Scientists now discovered how this resistance is established. They published their findings in the scientific journal Science.
Why scientists need to create GMOs for their research in the lab
Genetically modified organisms (GMOs) are powerful tools that help scientists study the foundation of life. The knowledge that can be created with them is the basis for applications everyone can benefit from. It can be the cure of a disease or the cure of hunger. The GMOs are made to be used in a laboratory,…



![[Small bite] Why are leaves green?](https://sciencebites.science.blog/wp-content/uploads/2022/01/tree_new.jpg?w=800&h=600&crop=1)